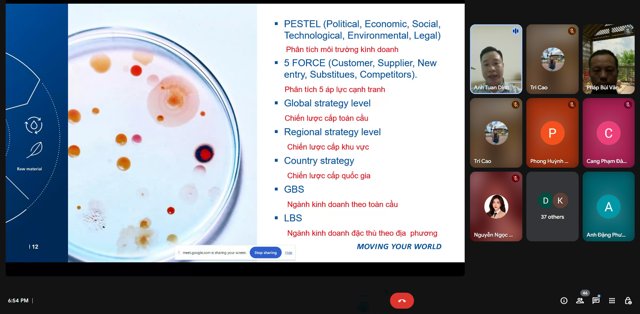

VIỆN ĐÀO TẠO SAU ĐẠI HỌC
Tin tức sự kiện Đào tạo sau đại học
VIỆN ĐÀO TẠO SAU ĐẠI HỌC - UEF 11 NĂM KIẾN TẠO TRI THỨC THỰC CHIẾN, HỘI NHẬP QUỐC TẾ
15/09/2025
Ngày 15 tháng 9 năm 2025, Viện Đào tạo Sau đại học – Trường Đại học Kinh tế - Tài chính TP.HCM (UEF) chính thức đánh dấu 11 năm hình thành và phát triển. Hành trình này không chỉ là cột mốc đáng tự hào, mà còn mở ra bước chuyển mình mạnh mẽ theo định hướng chuyên nghiệp, gắn liền thực tiễn và chuẩn quốc tế.
Khởi nguồn từ sứ mệnh lan tỏa tri thức ứng dụng
Thành lập từ năm 2014, Viện Đào tạo Sau đại học UEF đã không ngừng mở rộng quy mô, nâng cao chất lượng chương trình và định vị rõ nét uy tín học thuật của mình trong hệ thống giáo dục bậc cao. Viện đã trở thành môi trường học thuật chuyên sâu – nơi người học được tiếp cận tri thức theo hướng ứng dụng thực tế, gắn kết doanh nghiệp và cập nhật toàn cầu.

Lễ Khai giảng đào tạo trình độ Tiến sĩ, Thạc sĩ năm 2025
Chương trình đào tạo: Chuyên nghiệp – Linh hoạt – Hội nhập
Hiện nay, Viện triển khai 6 chương trình Thạc sĩ (Quản trị kinh doanh, Tài chính – Ngân hàng, Kế toán, Ngôn ngữ Anh, Luật Kinh tế, Quan hệ công chúng) và 2 chương trình Tiến sĩ (Quản trị kinh doanh, Luật Kinh tế).
Các chương trình được thiết kế theo lộ trình khoa học, linh hoạt, cân bằng giữa lý thuyết chuyên sâu và kỹ năng thực hành. Học viên không chỉ học để biết, mà học để ứng dụng giải quyết vấn đề thực tế trong môi trường kinh doanh, pháp lý, truyền thông...
Định hướng quốc tế hóa chương trình cũng đang được đẩy mạnh, tạo cơ hội cho người học tiếp cận các chuẩn mực học thuật toàn cầu và mở rộng cánh cửa nghề nghiệp trong môi trường quốc tế.



Các Tiến sĩ và Thạc sĩ đã tham dự Lễ tốt nghiệp đợt 2-2025 vào ngày 28/08/2025
Không gian học thuật hiện đại, gắn liền thực tiễn
Điểm khác biệt tại Viện đến từ mô hình đào tạo thực chiến: liên tục tổ chức hội thảo chuyên đề chuyên sâu với chuyên gia trong và ngoài nước, kết nối doanh nghiệp, thực hiện đề tài nghiên cứu ứng dụng, hoạt động học thuật kết hợp cộng đồng.

Các hoạt động chuyên đề thực tế cùng chuyên gia được tổ chức online và offline cho học viên
Đội ngũ giảng viên là chuyên gia giàu kinh nghiệm nghiên cứu và thực tiễn, đồng hành cùng học viên như những người hướng dẫn phát triển năng lực chuyên môn và tư duy phản biện.
Cổng dịch vụ trực tuyến UEF ID – công cụ hỗ trợ học tập hiện đại – cũng đã được đưa vào sử dụng, giúp học viên quản lý học vụ dễ dàng, linh hoạt tiếp cận tài liệu, lớp học và thông tin học thuật ở bất cứ đâu. Đây là một phần trong chiến lược chuyển đổi số toàn diện, tối ưu hóa trải nghiệm học tập chuyên nghiệp.

Cổng dịch vụ trực tuyến UEF ID
Cộng đồng học thuật – kết nối, phát triển, sẻ chia
Viện không chỉ chú trọng đào tạo, mà còn nuôi dưỡng tinh thần công dân toàn cầu và trách nhiệm xã hội thông qua các chương trình thiện nguyện, thể thao, văn hóa – xây dựng cộng đồng học viên – cựu học viên – giảng viên – doanh nghiệp gắn kết chặt chẽ.
Đây là nơi không chỉ đào tạo nhân lực, mà còn truyền cảm hứng phát triển bền vững trong hành trình học thuật và nghề nghiệp.

Hoạt động từ thiện tại phường La Gi, tỉnh Lâm Đồng
HƯỚNG TỚI MỘT MÔI TRƯỜNG ĐÀO TẠO SAU ĐẠI HỌC THỰC TIỄN VÀ HỘI NHẬP
Với những nền tảng ban đầu cùng định hướng phát triển rõ ràng, Viện Đào tạo Sau đại học UEF đang không ngừng nỗ lực hoàn thiện mình trong hành trình góp phần đào tạo nguồn nhân lực chất lượng, phù hợp với nhu cầu thực tiễn và xu hướng hội nhập quốc tế.
Hành trình 11 năm qua là bước khởi đầu đáng trân trọng, và đồng thời cũng là động lực để Viện tiếp tục nâng cao tính chuyên nghiệp, tăng cường yếu tố thực tiễn trong chương trình đào tạo và từng bước mở rộng kết nối toàn cầu một cách sâu sắc và hiệu quả hơn.
TIN LIÊN QUAN
Lịch sự kiện đang được cập nhật...






